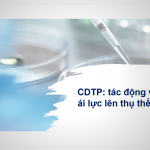

The Blogs
Full bộ Tài liệu: Khóa 04 – Tập huấn online về Phỏng vấn tạo động lực (Tháng 04-06/2020)
Từ ngày 22/04 đến ngày 17/06/2020, Trung tâm VHATTC – Đại học Y Dược TP. HCM đã tổ chức thành công 7 buổi giảng trực tuyến trong khóa thứ 4 – Đào tạo và cấp chứng chỉ về Kỹ thuật phỏng vấn tạo động lực (Motivational Interviewing) cho hơn 50 cán bộ đang làm việc … Continue reading Full ...
Tài liệu khóa tập huấn thứ 1- Can thiệp giảm nguy cơ của Chemsex trên nhóm MSM và TG (Tháng 05/2020)
Document and video of online lecture on " COVID-19 Prevention in health approaching and caring in the community" (29 April 2020)
Kính chào quý đồng nghiệp, Trân trọng cảm ơn quý vị đồng nghiệp đã tham gia vào buổi giảng trực tuyến về “Dự phòng COVID -19 trong công tác tiếp cận và chăm sóc tại cộng đồng” do TS. Đỗ Văn Dũng (Trưởng Khoa Y tế Công cộng, Trưởng Trung tâm VHATTC – Đại học Y Dược … Continue reading Tài ...
Document and Video Lecture on Guidance for Providing Methadone and Buprenorphine in COVID-19 Emergency (15 April, 2020)
Trân trọng cảm ơn quý vị đồng nghiệp đã tham gia vào buổi giảng trực tuyến về “Hướng dẫn cấp phát thuốc Methadone và Buprenorphine trong giai đoạn dịch COVID-19” do TS. BS. Hoàng Đình Cảnh (Phó cục trưởng – Cục Phòng, chống HIV/AIDS (Bộ Y tế)) trình bày vào chiều ngày 15/04/2020 vừa qua. Vì thời gian buổi giảng có … Continue reading Tài ...
Tài liệu và Video toàn bộ Khóa học điều trị Methadone căn bản – Lớp định hướng (Ngày 06/04 -10/04/2020)
Từ ngày 06/04 đến ngày 10/04/2020, Trung tâm VHATTC – Đại học Y Dược TP. HCM đã tổ chức thành công chuỗi 5 buổi giảng trực tuyến của Lớp định hướng thuộc Khoá tập huấn căn bản điều trị bằng Methadone cho khoảng 100 học viên là các cán bộ đang hoặc chuẩn bị làm … Continue reading Tài ...
Document and Video Lecture on Infection Prevention and Control for COVID-19 at Methadone Clinics and other Health Facilities (01 April, 2020).
Trân trọng cảm ơn quý vị đồng nghiệp đã tham gia vào buổi giảng trực tuyến về “Kiểm soát lây nhiễm COVID-19 tại phòng khám Methadone và các Cơ sở Y tế khác do PGS. Đỗ Văn Dũng (Trưởng Khoa Y tế Công cộng, Trưởng Trung tâm VHATTT – Đại học Y Dược TP.HCM) trình … Continue reading Tài ...
Document and video of Online Lecture on: “Methadone,Buprenorphine, Naltrexone: The choice for heroin addiction”
Trân trọng cảm ơn quý vị anh chị đã tham gia vào buổi giảng trực tuyến về chủ đề “Methadone, Buprenorphine, Naltrexone: Lựa chọn nào cho người sử dụng Heroin” với ThS. BS. Nguyễn Song Chí Trung (Khoa Y, Đại học Y Dược TP. HCM) ThS. BS. Đoàn Trúc Quỳnh (Khoa Y, Đại học Y … Continue reading Tài ...
Document and video of the Online training on Gambling Disorder (Feb 20, 2020)
Trân trọng cảm ơn quý vị anh chị đã tham gia vào buổi giảng trực tuyến về Chứng nghiện cờ bạc với TS. Sue Bertossa (Giám đốc Trung tâm Chăm sóc sức khỏe Flinders, Đại học Flinders, Australia) và ThS. Mỹ Phương Sramek (Giám Đốc Dịch Vụ Hỗ Trợ Tiếp Cận Cộng Đồng Nam Australia, … Continue reading Tài ...